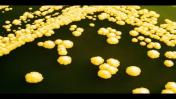
הזדקנות תאית - מחקר שלא קופא על השמרים

סרטון אחד
מחקרים ברשת
38 סרטונים
איך חוזים סופות באמצעות ברקים? מה אפשר ללמוד מעצמות בנות אלפי שנים? ומה ניתן ללמוד מחיידקים על קבלת החלטות? צפו בסדרת סרטונים על מגוון תחומי הפעילות האקדמיים והמחקרים המדעיים של החוקרים שלנו
כל הזכויות שמורות
האם ישנם הבדלים בין מוח נשי למוח גברי? האם התנהגות "גברית" או "נשית" טמונה במבנה המוח או תלויית תרבות? פרופ' דפנה יואל מביה"ס למדעי הפסיכולוגיה מערערת על התפיסה "נשים מנגה, גברים ממאדים".